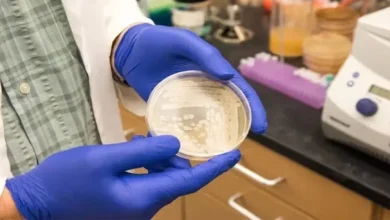

سپیشل رپورٹ
-

غزہ کی صورت حال کا ذمہ دار یہودی مذہب نہیں، اسرائیلی حکومت ہے: ڈاکٹر محمد العیسی
رابطہ عالم اسلامی کے سیکرٹری جنرل ڈاکٹر محمد العیسی نے کہا ہے کہ غزہ میں درپیش صورتحال کے ذمہ دار…
یہ بھی پڑھیے: -

کراچی، بوہری برادری آج عیدالفطر منارہی ہے
بوہری برادری عیدالفطر آج جوش و خروش سے منا رہی ہے۔ کراچی میں صدر کی طاہری مسجد میں عیدالفطر کی…
یہ بھی پڑھیے: -

کس ملک کے پاس سب سے زیادہ لڑاکا طیارے ہیں؟
آج کی مارڈرن اور جدید دنیا میں لڑاکا طیارے کسی بھی ملک کی فضائیہ میں ریڑھ کی ہڈی کی حیثیت…
یہ بھی پڑھیے: -

جانیے! امریکہ اسرائیل کو کیسے اور کونسی فوجی مدد فراہم کرتا ہے؟
غزہ میں بڑے پیمانے پر انسانی تباہی کی وجہ سے واشنگٹن سے یہ مطالبہ کیا جا رہا ہے کہ وہ…
یہ بھی پڑھیے: -

سعودی عرب میں چاند نظر نہیں آیا, عیدالفطر 10 اپریل بروز بدھ کو ہو گی
سعودی عرب میں چاند نظر نہیں آیا جس کے بعد سلطنت میں عیدالفطر 10 اپریل بروز بدھ منائی جائے گی۔…
یہ بھی پڑھیے: -

‘جس کو لگتا ہے کہ قانون کے مطابق داد رسی نہیں ہوئی تو قیامت کے دن حاضر ہوں’
چیف جسٹس پشاور ہائیکورٹ محمد ابراہیم خان کا کہنا ہے کہ ہم نے قانون کے مطابق فیصلے کیے مگر ہمیں…
یہ بھی پڑھیے: -

ہاتھ سے لکھنا دماغ کے لیے کتنا فائدہ مند ہوتا ہے؟ حیران کن تحقیق
موجودہ دور میں ہاتھ سے لکھنے والوں کی تعداد کافی کم ہوگئی ہے تاہم ہاتھ سے لکھنا دماغ کے لیے…
یہ بھی پڑھیے: -

عید کی چھٹیوں پر گھر چھوڑنے سے قبل کیا احتیاطی تدابیر کریں؟ پولیس حکام نے بتا دیا
عید کی چھٹیوں پر جانے کے لیے گھر چھوڑنے سے قبل احتیاطی تدابیر ضروری ہیں، اس سلسلے میں ڈی آئی…
یہ بھی پڑھیے: -

نوڈل لینے گیا، واپس آیا تو والدین کفن میں ملے: فلسطینی بچہ
غزہ میں اسرائیلی فوج کی بم باری سے کئی خاندان اجڑ گئے۔ غیر ملکی میڈیا کے مطابق غزہ میں سیکڑوں…
یہ بھی پڑھیے: -

ہم نے بھارت کا جہاز گرایا تھا اور پائلٹ کو پکڑ کر خیرات میں واپس کیا تھا، خواجہ آصف
وزیر دفاع خواجہ آصف نے کہا ہے کہ بھارتی وزیر دفاع راج ناتھ سنگھ الیکشن مہم کی وجہ سے بڑھکیں…
یہ بھی پڑھیے: -

ادھار پر چائے پلانے والے وزیر اعظم آفس کے افسران کو چار اضافی تنخواہوں کی منظوری
آئی ایم ایف بیل آؤٹ پیکیج سے قبل وزیراعظم آفس کے افسران کیلیے 4 اضافی تنخواہوں کی منظوری دیدی گئی۔…
یہ بھی پڑھیے: -

ڈویژنل لیول پر خواجہ سراؤں کیلئے اسکول قائم کیے جائیں گے
وزیراعلیٰ پنجاب کی زیر صدارت اجلاس میں اسکول ایجوکیشن ریفارمز کا جائزہ لیا گیا۔ اس موقع پر مریم نواز نے…
یہ بھی پڑھیے: -

کیا KPK کابینہ اجلاس کور کمانڈر ہاؤس پشاور میں ہوا تھا؟
کیا خیبرپختونخوا کابینہ کا اجلاس کور کمانڈر ہائوس پشاور میں ہوا تھا؟کیا صوبائی وزیراعلیٰ علی امین گنڈا پور پوری کابینہ…
یہ بھی پڑھیے: -

بھارتی خفیہ ایجنسی نے 2020 سے اب تک پاکستان میں 20 افراد کو قتل کروایا، برطانوی اخبار
برطانوی اخبار گارڈین نے انکشاف کیا ہے کہ بھارتی خفیہ ایجنسی نے 2020 سے اب تک پاکستان میں 20 افراد…
یہ بھی پڑھیے: -

کھانے میں زہر دیا گیا یا نہیں؟ بشریٰ بی بی کی میڈیکل رپورٹ آگئی
بشریٰ بی بی کی میڈیکل رپورٹ سامنے آگئی جس میں انھیں کھانے میں زہر یا ٹوائلٹ کلینر دینے کے شواہد…
یہ بھی پڑھیے: -
ججز کے خطوط سے ملنے والے پاؤڈر کی فارنزک رپورٹ میں نیا انکشاف
ہائیکورٹ ججز کو بھجوائے گئے خطوط کی تفتیش میں پیش رفت ہوئی ہے، خطوط سے ملنے والے پاؤڈر کی فارنزک…
یہ بھی پڑھیے: -

حافظ نعیم الرحمٰن ۔ ایک تعارف
پیدائش اور خاندانی پس منظر ■ امیر جماعت اسلامی کراچی حافظ نعیم الرحمٰن 1972 میں حیدرآباد، سندھ میں ایک متوسط…
یہ بھی پڑھیے: -

گیس چوری کریک ڈاؤن: 34گیس کنکشن منقطع، 17 لاکھ سے زائد کے جرمانے
(لاہور) سوئی ناردرن کے تحت پنجاب، خیبر پختونخواہ اور اسلام آباد کے مختلف علاقوں میں گیس چوری کے خلاف جاری…
یہ بھی پڑھیے: -

جو کہا اس پر اصولی اسٹینڈ لیا، جو کہنا تھا خط میں لکھ دیا، تصدق جیلانی
جسٹس (ر) تصدق جیلانی نے کہا ہے کہ آج بھی عدلیہ کے کوڈ آف کنڈکٹ کا پابند ہوں، جو کہا…
یہ بھی پڑھیے: -

دُنیا کے 10 امیر ترین کھرب پتیوں میں پہلا نمبر کس کا؟
امریکی جریدے فوربزنے دنیا کی امیر ترین کھرب پتی شخصیات کی فہرست جاری کردی ہے۔ فرانسیسی کاروباری شخصیت برنالڈ ارنالٹ…
یہ بھی پڑھیے:
